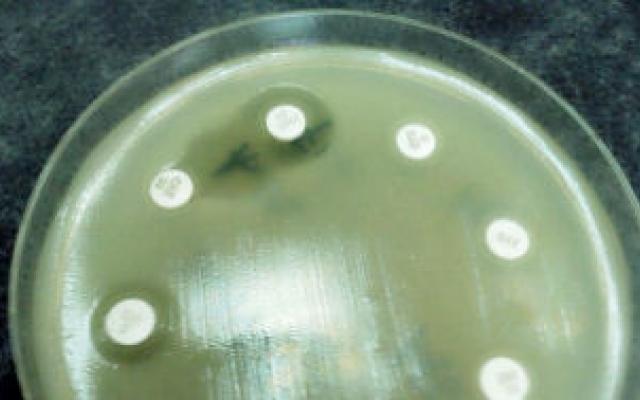

Samenvatting
Doel
Bepalen welke ‘extended’-spectrum-bètalactamase(ESBL)-genen en plasmiden aanwezig zijn in Escherichia coli in vleeskuikens en vers kippenvlees uit Nederland en tevens in een voor Nederland representatieve collectie van klinische E. coli isolaten van patiënten.
Opzet
Beschrijvend.
Methoden
ESBL-producerende E. coli-isolaten waren afkomstig van 98 kipfilets, een ESBL-surveillance studie bij vleeskuikens uit 2006 en 516 humane klinische isolaten uit 31 laboratoria verzameld gedurende een periode van 3 maanden in 2009. De distributie werd vastgesteld van ESBL-genen en plasmiden in E. coli aanwezig in vleeskuikens en vers kippenvlees en de gevonden ESBL-genen werden gedefinieerd als ‘kip-geassocieerd’. In een voor Nederland representatieve steekproef van klinische E. coli-isolaten werd het aandeel van kip-geassocieerde ESBL-genen en plasmiden gekwantificeerd. De isolaten werden geanalyseerd met een ESBL-specifieke microarray, een ESBL-gensequentiebepaling, en 2 plasmide-typeringsmethoden: zogenaamde PCR-gebaseerde replicon-typering en plasmide-multi-locussequentietypering.
Resultaten
6 ESBL-genen werden aangemerkt als ‘kip-geassocieerd’: bla CTXM-1, bla CTXM-2, bla SHV-2, bla SHV-12, bla TEM-20, bla TEM-52. Van de humane ESBL-producerende isolaten bevatte 35% een kip-geassocieerd ESBL-gen, en 19% een kip-geassocieerd ESBL-gen gelegen op een IncI1-plasmide, dat genetisch niet te onderscheiden was van plasmides afkomstig van vleeskuikens. In humane isolaten met een kip-geassocieerde ESBL’s waren bla CTXM-1 en bla TEM-52 de meest prevalente ESBL-genen (86%), net als in de isolaten van vleeskuikens (78%) en kipfilets (75%). Van de 98 kipfilets bevatte 94% een ESBL producerende E. coli.
Conclusie
Deze bevindingen zijn suggestief voor overdracht van ESBL producerende E. coli van pluimvee naar de mens via de voedselketen.

Reacties